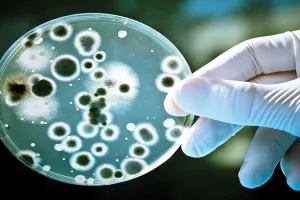
इंडोनेशिया ने रोगाणुरोधी प्रतिरोध की निगरानी के किफायती तरीके का किया परीक्षण, संयुक्त राष्ट्र ने दी चेतावनी

स्पेशल न्यूज
Effective
<% catList.forEach(function(cat){ %> <%= cat.label %> <% }); %>
<%- node_title %>
Published On
By <%= createdBy.user_fullname %>
<%- node_title %>
Published On
By <%= createdBy.user_fullname %>
<% if(node_description!==false) { %> <%= node_description %>
<% } %> <% catList.forEach(function(cat){ %> <%= cat.label %> <% }); %>
इंडोनेशिया ने रोगाणुरोधी प्रतिरोध की निगरानी के किफायती तरीके का किया परीक्षण, संयुक्त राष्ट्र ने दी चेतावनी
Published On
By Priya
बांडुंग। इंडोनेशिया के शोधकर्ताओं ने रोगाणुरोधी प्रतिरोध की निगरानी के एक किफायती तरीके का परीक्षण किया है जो विकासशील देशों के लिए एक महत्वपूर्ण उपकरण हो सकता है। इंडोनेशिया के शोधकर्ताओं ने रोगाणुरोधी प्रतिरोध में परिवर्तन को मापने के लिए...
Depression के लिए Counseling या Medication से भी अधिक Effective है Exercise, लेकिन ध्यान रखें ये बात
Published On
By Himanshu Bhakuni
(बेन सिंह, कैरोल माहेर और जैसिंटा ब्रिंसले, दक्षिण ऑस्ट्रेलिया विश्वविद्यालय) सिडनी, (द कन्वरसेशन)। दुनिया वर्तमान में एक मानसिक स्वास्थ्य संकट से जूझ रही है, जिसमें लाखों लोग अवसाद, चिंता और अन्य मानसिक स्वास्थ्य समस्याओं की शिकायत कर रहे हैं। हाल...
अयोध्या: आरपार की लड़ाई के मूड में शिक्षक संघ, संगठन को प्रभावी बनाने के लिए बनाए गए तहसील प्रभारी
Published On
By Deepak Mishra
अयोध्या, अमृत विचार। वेतन और शिक्षकों के विभिन्न मुद्दों को लेकर अब उत्तर प्रदेश प्राथमिक शिक्षक संघ आरपार की लड़ाई के मूड में आ गया है। संघ ने संगठन को और अधिक सक्रिय और मजबूत करने के लिए जिले की...
भारत-ऑस्ट्रेलिया मुक्त व्यापार समझौता 29 दिसंबर से प्रभावी होगा : पीयूष गोयल
Published On
By Ashpreet
नई दिल्ली। केंद्रीय मंत्री पीयूष गोयल ने शुक्रवार को राज्यसभा में कहा कि भारत-ऑस्ट्रेलिया मुक्त व्यापार समझौता (एफटीए) 29 दिसंबर से प्रभावी हो जाएगा और ब्रिटेन, कनाडा सहित कई देशों के साथ इस संबंध में बातचीत चल रही है। गोयल...
हल्द्वानी: घबराए नहीं लंपी बीमारी में आईवीआरआई मुक्तेश्वर द्वारा विकसित गोट पॉक्स वैक्सीन है प्रभावी
Published On
By Amrit Vichar
भूपेश कन्नौजिया, हल्द्वानी। इन दिनों लंपी बीमारी को लेकर पूरे देश में कहर मचा हुआ है। इस विषाणुजनित बीमारी का संक्रमण दर काफी तेज है। इस वायरस के बारे में कहा जा रहा है कि इस बीमारी का आगमन विदेश से भारत में हुआ है। वर्ष 2019 में उड़ीसा में पहली बार इस बीमारी का …
लैंसेट अध्ययन के अनुसार, कुछ एंटीवायरल दवाएं मंकीपॉक्स के लिए कारगर
Published On
By Amrit Vichar
नई दिल्ली। ब्रिटेन में वर्ष 2018 और 2021 के बीच दुर्लभ संक्रामक रोग मंकीपॉक्स से ठीक हुए सात मरीजों पर किए गए एक अध्ययन से यह पता चला है कि कुछ एंटीवायरल दवाओं में मंकीपॉक्स के लक्षणों और रोगी के संक्रमण की अवधि को कम करने की क्षमता हो सकती है। ‘द लैंसेट इन्फेक्शियस डिजीज’ …
रायबरेली: टीबी मरीजों को अब नहीं लगाना होगा इंजेक्शन, बेडा कुलीन दवा है कारगर
Published On
By Amrit Vichar
रायबरेली। टीबी के मरीजों को अब इंजेक्शन की जरूरत नहीं है। अब ऐसी दवा आ गई है, जिसके खाने से टीबी से छुटकारा मिलेगा। मंगलवार को जिला क्षयरोग केंद्र रायबरेली में जिला क्षय रोग अधिकारी क्षयरोग हेतु क्षयरोग उन्मूलन कार्यक्रम के अंतर्गत महत्वपूर्ण दवा बेडाकुलीन की शुरुआत की गई है। जिसके अंतर्गत एमडीआर मरीज जो …
गरीबों को कारगर चिकित्सा दें होम्योपैथिक चिकित्सक : आनंदीबेन पटेल
Published On
By Amrit Vichar
लखनऊ। राज्यपाल आनंदीबेन पटेल ने कहा कि होम्योपैथिक चिकित्सक गरीब महिलाओं व बच्चों को कारगर चिकित्सा मुहैया कराने का कार्य करें। राज्यपाल रविवार को राजभवन से इंडियन इंस्टीट्यूट ऑफ होम्योपैथिक फिजीशियन की आगरा शाखा द्वारा आगरा में आयोजित अंतरराज्यीय होम्योपैथिक कांफ्रेन्स को वर्चुअली सम्बोधित कर रहे थे। बतौर मुख्य अतिथि राज्यपाल ने कहा कि एक …
मतदाता जागरूकता कार्यक्रम को और प्रभावी बनाया जाए : निर्वाचन अधिकारी
Published On
By Amrit Vichar
लखनऊ। एक नवंबर को मतदाता सूची का प्रकाशन और 30 नवंबर तक दावे और आपत्तियां ली जाएंगी। सभी बीएलओ मतदाता पुनरीक्षण कार्यक्रम के प्रति लोगों को जानकारी दें। पात्र का नाम मतदाता सूची में शामिल होने से न छूटे। उक्त बातें अपर मुख्य निर्वाचन अधिकारी डा. ब्रह्म राम देव तिवारी ने विधानसभा मतदाता सूची का …
डेल्टा स्वरूप के खिलाफ कारगर है कोविड टीका, भारत के बाद अब ब्रिटेन में भी हुई पुष्टि
Published On
By Amrit Vichar
लंदन। कोविड-19 के डेल्टा स्वरूप के खिलाफ टीके की दो खुराक काफी प्रभावी हैं। इस बारे में पहले भारत में पता चला और अब ब्रिटेन में हुए एक अध्ययन में भी इस निष्कर्ष पर पहुंचा गया है। ऑक्सफोर्ड विश्वविद्यालय के वैज्ञानिकों के अध्ययन में पाया गया कि फाइजर/बायोएनटेक और ऑक्सफोर्ड/एस्ट्राजेनेका के टीके नए संक्रमण से …
कोराेना संक्रमण की रोकथाम में कारगर है ये खास वैक्सीन, सुई की चुभन नहीं होती महसूस
Published On
By Amrit Vichar
लंदन। वैज्ञानिकों ने कहा है कि नाक के जरिये लगाया जाने वाला कोविड-19 टीका पशुओं पर किये गए प्री-क्लीनिकल ट्रायल में बीमारी के प्रभाव और वायरस के संक्रमण दोनों को कम करने में सक्षम पाया गया है। ब्रिटेन के लैंकास्टर विश्वविद्यालय के अनुसंधानकर्ताओं ने चूहों को इस टीके की दो खुराकें दी। इसके बाद उन्होंने …
रिसर्च में दावा, covid-19 के डेल्टा वैरिएंट के खिलाफ प्रभावी है भारत बॉयोटेक की वैक्सीन
Published On
By Amrit Vichar
हैदराबाद। कोरोना संकट के बीच तेजी से वैक्सीनेशन प्रोग्राम (Corona Vaccination) पूरे देश में जारी है। इस बीच एक बड़ी खबर सामने आई है। भारतीय चिकित्सा अनुसंधान परिषद (आईसीएमआर) द्वारा बायोरक्सिव में प्रकाशित एक अध्ययन के अनुसार भारत बॉयोटेक (Bharat Biotech) का कोविड-19 टीका कोवैक्सीन (बीबीवी152) कोरोना वायरस के डेल्टा प्लस (एवाई.1) (Delta Plus Variant) स्वरूप …

8.png)




1.png)
.jpg)
3.png)
